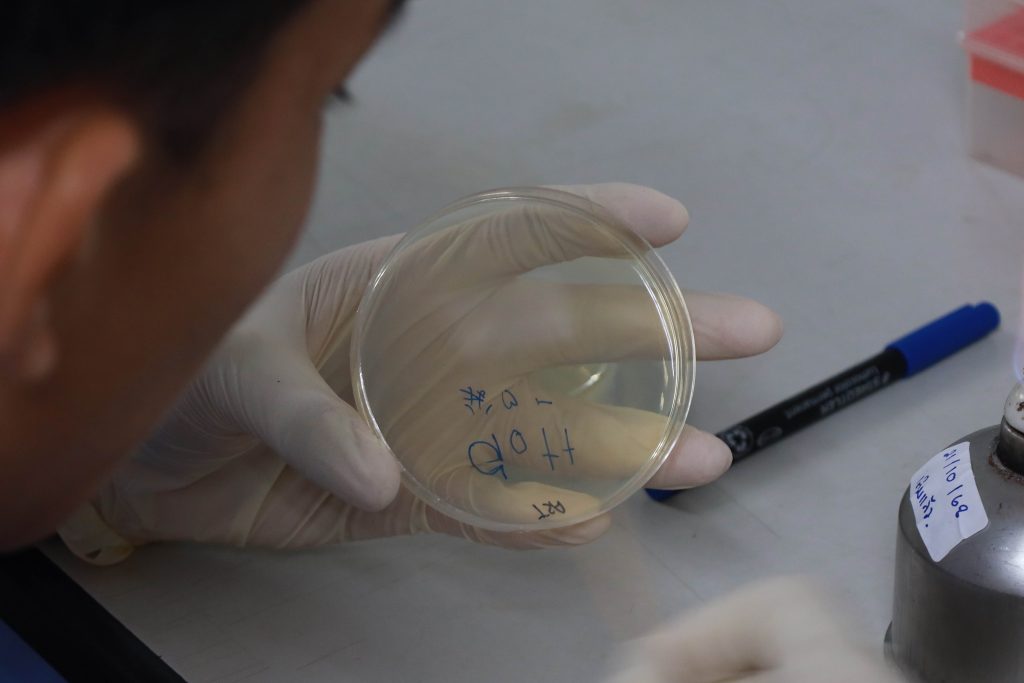

รศ.ดร.สุระสิทธิ์ ทรงม้า รองคณบดีคณะวิทยาศาสตร์และเทคโนโลยีและ ผศ.ดร.อุดมศักดิ์ กิจทวี ผู้ช่วยคณบดี กล่าวเปิดงาน “การอบรมเชิงปฏิบัติการ ด้านวิทยาศาสตร์ การแพทย์ อุตสาหกรรมชีวภาพและปัญญาประดิษฐ์” และมีการฝึกปฎิบัติการด้านการทดสอบความไวของเชื้อต่อยาด้วยวิธี Disk agar diffusion method และการย้อมสีแกรมของแบคทีเรีย การผลิตโยเกิร์ตโฮมเมดและมาตรฐานการผลิตผลิตภัณฑ์ชีวภาพ สำหรับนักเรียนโรงเรียนสตรีวิทยา 2 ในพระราชูปถัมภ์ฯ กรุงเทพมหานคร จำนวน 39 คน วันที่ 18 พฤศจิกายน 2568 ณ Co-Working Space ชั้น 5 ศูนย์วิทยาศาสตร์ฯ ถนนสิรินธร มหาวิทยาลัยสวนดุสิต กรุงเทพฯ